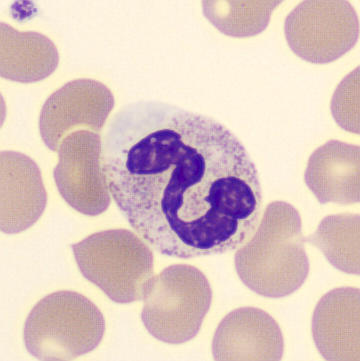
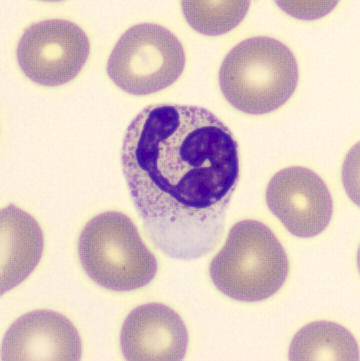
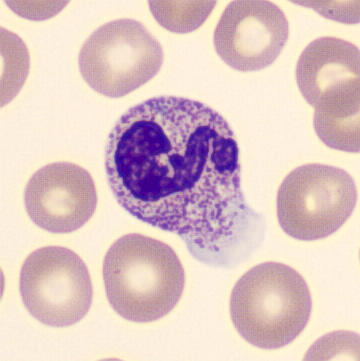
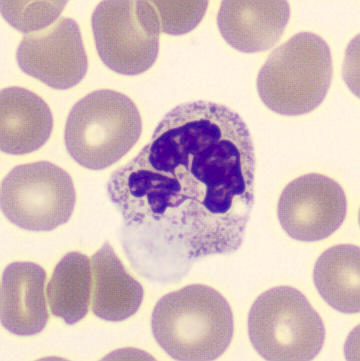
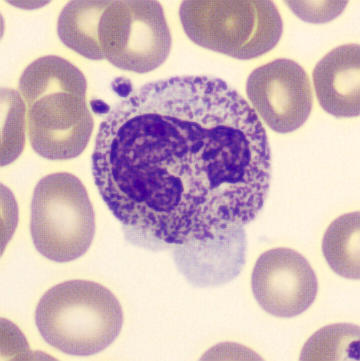
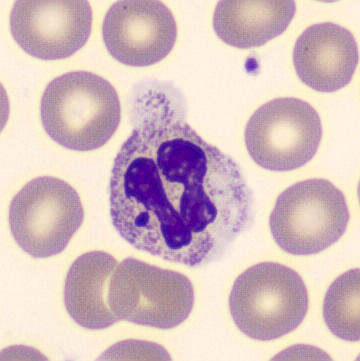
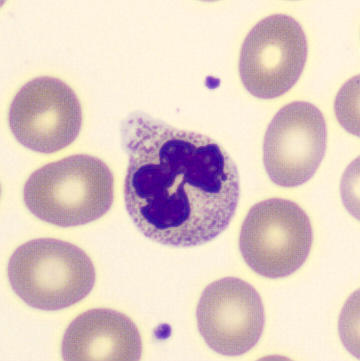
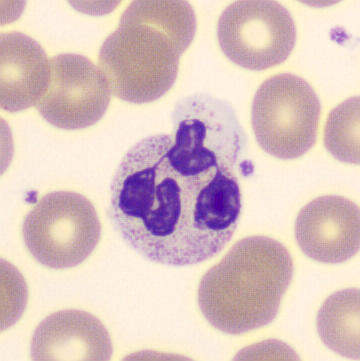
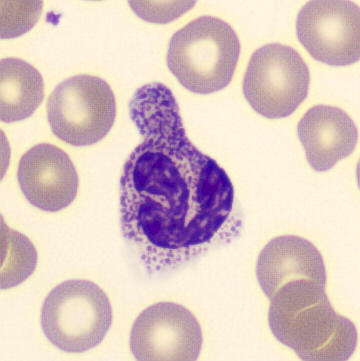
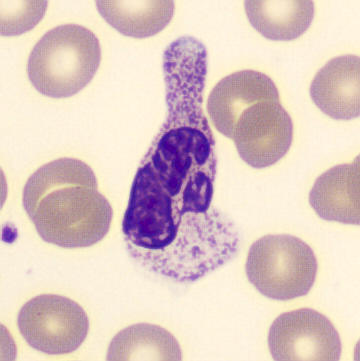
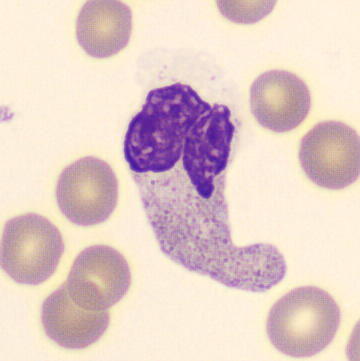
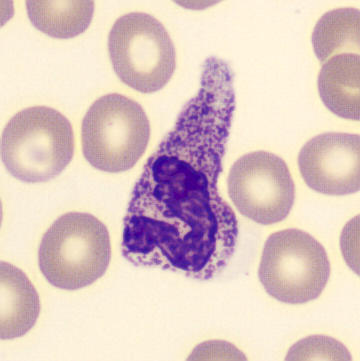
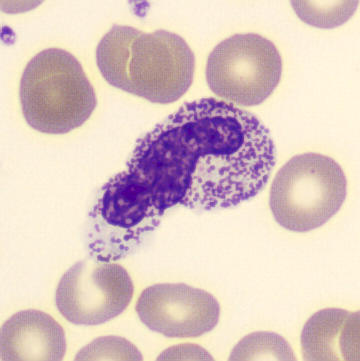

Pseudopod
Synonyms: Blebs, Lamellipodium
Neutrophils can sometimes display round protrusions of the cytoplasm. Possibly these are pseudopodia involved in migration and phagocytosis. Anecdotally, these phenomena are often accompanied by other signs of activation, such as hypergranulation and/or vacuolization. However, the clinical relevance of this phenomenon is unclear, as it is rarely described in the literature.
Variant I

Variant II